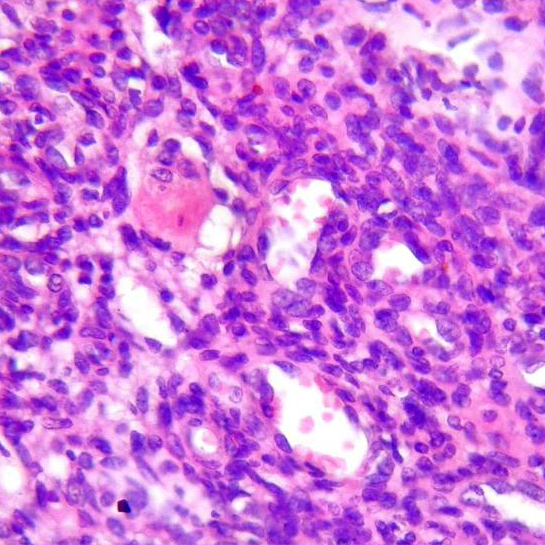
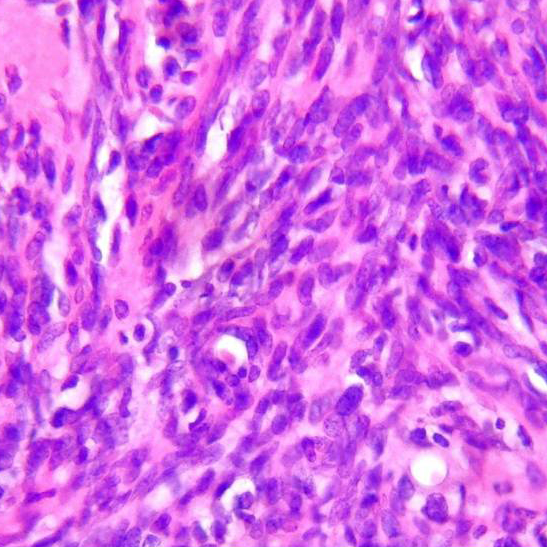

Descripción:
Mujer de 43 años consultó por dolores óseos severos que limitaban la deambulación, se movilizaba en silla de ruedas y utilizaba “Corset” por el intenso dolor.
Al examen físico se detectó un nódulo de 2 cm superficial y móvil en región subcostal izquierda.

Se recibe pieza de nodulectomía. A la inspección macroscópica era un nódulo sólido bien circunscripto, blanquecino con áreas quísticas y hemorrágicas.
Imágenes Microscopio
H/E 10 x
H/E 10 x
H/E 10 x
H/E 40 x
H/E 40 x
¿En que patología pensarías?
A- Fibroma Osificante.
B- Osteosarcoma.
C- Tumor Fibroso Solitario.
D- Tumor Mesenquimal Fosfatúrico.
E- Granuloma Reparativo.
RESOLUCIÓN DEL CASO
LABORATORIO
Aumento de PTH y FAL, Hopofosfatemia Severa y Fosfaturia
Inmunohistoquímica
FGF-23: Positivo
FGF-23: Positivo
DIAGNÓSTICO
TUMOR MESENQUIMAL FOSFATÚRICO
• Es una neoplasia mesenquimal que afecta al hueso y el tejido blando, se asocia con hiperfosfaturia e hipofosfatemia. Causa predominantemente de osteomalacia inducida por tumores oncogénicos (TIO) por sobreproducción del factor de crecimiento de fibroblastos 23 (FGF-23).
• Puede afectar cualquier región de tejido blando, afectando principalmente extremidades y zonas acras
• Curso benigno.
• Macroscópicamente: Bien circunscriptos con áreas quísticas y hemorrágicas.
• Microscópicamente: Proliferación de células fusiformes con celularidad baja a moderada, áreas de morfología osteoide; pueden estar presentes células gigantes similares a osteoclastos. Las células tumorales producen una sustancia similar a la hormona peptídica factor de crecimiento fibroblástico 23 (FGF 23).
• La demostración de FGF23 (IHQ o RT-PCR) confirma la naturaleza fosfatúrica del tumor.
• Conclusión: En este caso la evolución clínica a partir del estudio de hipofosfatemia severa junto con el exhaustivo examen físico, con la localización tumoral, permitió la resolución del caso clínico en solo 2 meses.
• En el seguimiento de la paciente hubo un lapso de discontinuidad del tratamiento por parte de la misma con reaparición de una nueva lesión que se extrajo, de similares características. La paciente retomó el tratamiento y continúa asintomática hasta la fecha.